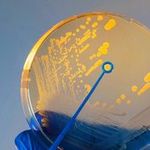

Pinnwand Universität, Kunst und Gestaltung, Medien, Piazza
Juliane Seeber:

Pinnwand Universität, Architektur und Urbanistik, Bau- und Umweltingenieurwissenschaften, Kunst und Gestaltung, Medien
Georgios Nikolas Paparoditis:
Pinnwand Architektur und Urbanistik, Bau- und Umweltingenieurwissenschaften, Biete / Suche
Katharina Cherubim:

Pinnwand Architektur und Urbanistik, Bau- und Umweltingenieurwissenschaften, Piazza
Katharina Wittke:
Pinnwand Universität
Sabine Herbst:
Pinnwand Universität, Kunst und Gestaltung, Internationales
Nassouri:

Pinnwand Universität, Piazza, Internationales
Michael Wallner:

Pinnwand Universität, Piazza, Internationales
Michael Wallner:

Pinnwand Universität, Architektur und Urbanistik, Bau- und Umweltingenieurwissenschaften, Kunst und Gestaltung, Medien, Piazza
Josephine Zorn:

Pinnwand Universität, Architektur und Urbanistik, Bau- und Umweltingenieurwissenschaften, Kunst und Gestaltung, Medien, Piazza
Josephine Zorn:

Pinnwand Universität, Architektur und Urbanistik, Bau- und Umweltingenieurwissenschaften, Kunst und Gestaltung, Medien
Vanessa Klaus:

Pinnwand Universität, Piazza, Internationales
Meeta Khurana-Wolff:

Pinnwand Architektur und Urbanistik, Bau- und Umweltingenieurwissenschaften, Kunst und Gestaltung, Medien, Internationales
Meeta Khurana-Wolff:

Pinnwand Piazza
BEST Masterclass | Deutschlandstiftung Integration:

Pinnwand Architektur und Urbanistik, Bau- und Umweltingenieurwissenschaften, Kunst und Gestaltung, Medien, Sprachen, Internationales
Meeta Khurana-Wolff:

Pinnwand Architektur und Urbanistik, Bau- und Umweltingenieurwissenschaften, Kunst und Gestaltung, Medien, Sprachen, Bibliothek, Internationales
Meeta Khurana-Wolff:

Pinnwand Universität, Piazza
Meeta Khurana-Wolff:
Pinnwand Universität, Biete / Suche, Wohnen, Internationales
Giulia Ferrara:
Wechsel zwischen Farb- und Schwarz-Weiß-Ansicht
Kontrastansicht aktiv
Kontrastansicht nicht aktiv
Wechsel der Hintergrundfarbe von Weiß zu Schwarz
Darkmode aktiv
Darkmode nicht aktiv
Fokussierte Elemente werden schwarz hinterlegt und so visuell hervorgehoben.
Feedback aktiv
Feedback nicht aktiv
Beendet Animationen auf der Website
Animationen aktiv
Animationen nicht aktiv